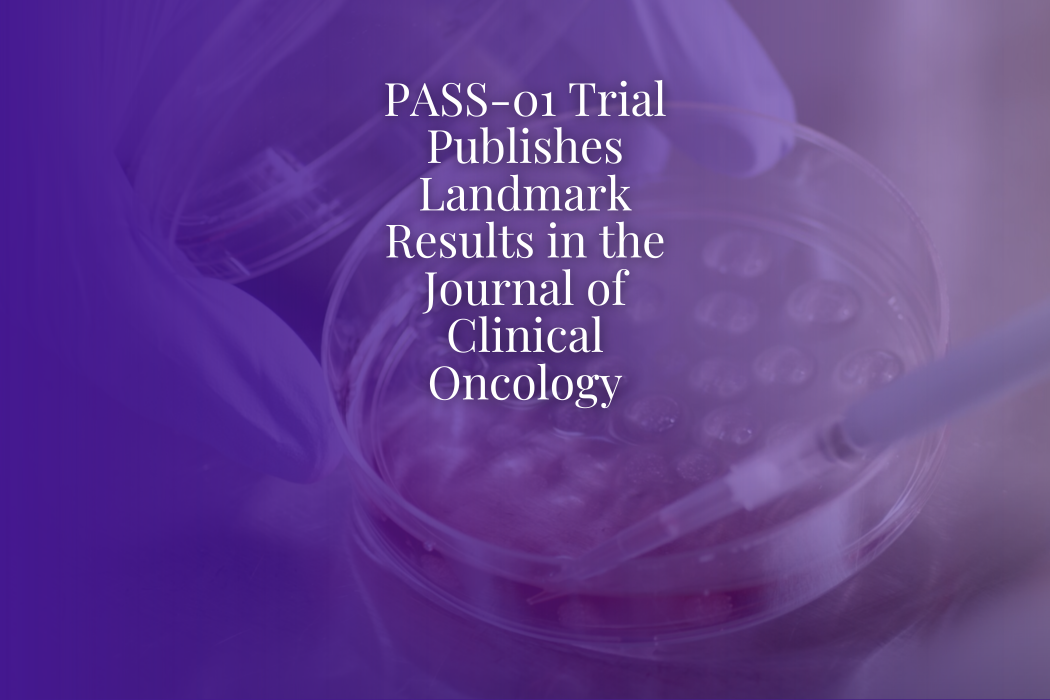
PASS-01 Trial Publishes Landmark Results in the Journal of Clinical Oncology

PASS-01 Trial Publishes Landmark Results in the Journal of Clinical Oncology
Topic: Hide on Homepage, News, Pancreatic Cancer News
The results of the Pancreatic Adenocarcinoma Signature Stratification for Treatment (PASS-01) clinical trial were published today in the Journal of Clinical Oncology, marking a major milestone in the pursuit of personalized medicine for pancreatic cancer.
PASS-01 is the first randomized, head-to-head comparison of the two current standard-of-care regimens for metastatic pancreatic cancer—modified FOLFIRINOX (mFFX) and gemcitabine/nab-paclitaxel (GnP). Beyond measuring treatment outcomes, PASS-01 set a new bar for what clinical trials in pancreatic cancer can achieve by pairing therapy response data with unprecedented molecular and genomic profiling of each patient’s tumor.
Key Findings
- 160 patients were randomized across six leading sites in the U.S. and Canada.
- Progression-free survival was similar between the two groups, but overall survival and safety trends favored GnP.
- Rapid molecular profiling revealed two distinct subtypes of pancreatic cancer—basal-like and classical. Patients with basal-like tumors responded poorly overall, but fared best with GnP.
- Because the profiling was done in real time, 44% of patients who moved to a second-line therapy were able to receive treatments guided by the study’s data.
Why PASS-01 Matters
The trial has created an unparalleled data resource that will continue to accelerate progress in the field. By linking genomic signatures to therapy response, PASS-01 is paving the way for a future in which pancreatic cancer patients are matched to treatments based on their molecular profile—improving outcomes, streamlining clinical trials, and bringing us closer to true personalized medicine.
A Model for the Future
PASS-01 redefined what’s possible in pancreatic cancer research. The trial was an international collaboration that required rapid data generation and sharing, coupled with innovative science like patient-derived organoids for drug testing. This integrated approach has set a new standard for how clinical trials can be designed and executed, offering a blueprint for future breakthroughs. The data and samples generated from PASS-01 will shape the field for years to come, driving discovery, informing trial design, and bringing us closer to a future where every patient receives the therapy best suited for their cancer.
Lustgarten’s Role
The PASS-01 study was supported by the Lustgarten Foundation and Stand Up To Cancer through the Pancreatic Cancer Collective, with additional support for organoid research at Cold Spring Harbor Laboratory through the Gail V. Coleman and Kenneth M. Bruntel Organoids for Personalized Therapy Grant.

